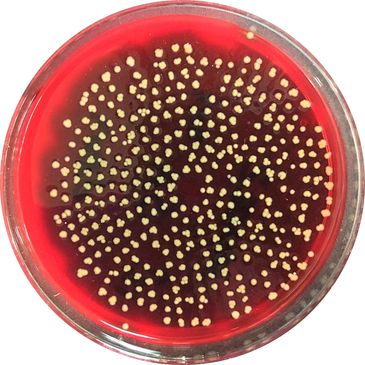
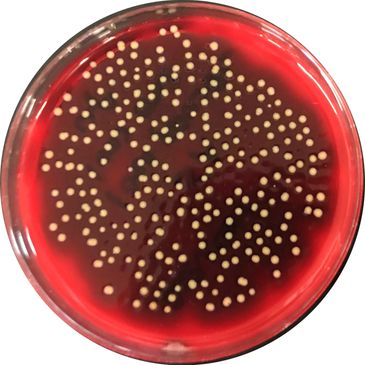

Signed in as:
filler@godaddy.com
Signed in as:
filler@godaddy.com
Staph aureus collected in a duct at 500cfm. No treatment of the air passing through the duct.
Staph aureus collected in a duct at 500cfm. Single pass treatment of the air using conventional UVC 254nm lamps.Results: less than 1% reduction.

Staph aureus collected in a duct at 500cfm. Single pass treatment of the air using Far-UV 222nm lamps. kResults: 99.9% reduction.
112 Corporate Drive, Suite 3, Portsmouth, NH 03801
We use cookies to analyze website traffic and optimize your website experience. By accepting our use of cookies, your data will be aggregated with all other user data.